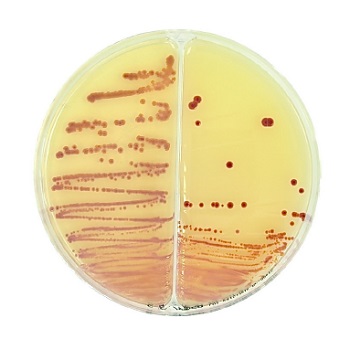

Cargando, por favor espere ...

Material para ensayos y análisis microbiológicos
| Código | Descripción | Disponibilidad | Precio 1x (€) |
Cantidad | Añadir |
|---|---|---|---|---|---|
| 2135101705 | Baird Parker / MacConkey, 20 plates 90 mm, Ready culture media in two sectors petri dishes, 50 cajas, LIOFILCHEM® | 5/12 días | 1.422,09 | 1 | |
| 2135101706 | Baird Parker / MacConkey, 100 plates 90 mm, Ready culture media in two sectors petri dishes, 10 cajas, LIOFILCHEM® | 5/12 días | 1.439,34 | 1 | |
| 2135101707 | Baird Parker / Sabouraud CAF, 20 plates, Ready culture media in two sectors petri dishes, 50 cajas, LIOFILCHEM® | 5/12 días | 1.422,09 | 1 | |
| 2135101708 | Baird Parker / Sabouraud CAF, 100 plates, Ready culture media in two sectors petri dishes, 10 cajas, LIOFILCHEM® | 5/12 días | 1.439,34 | 1 | |
| 2135101709 | Biggy (Nickerson) / Malt Agar, 20 plates 90 mm, Ready culture media in two sectors petri dishes, 40 cajas, LIOFILCHEM® | 5/12 días | 1.149,54 | 1 | |
| 2135101710 | Biggy (Nickerson) / Malt Agar, 100 plates 90 mm, Ready culture media in two sectors petri dishes, 8 cajas, LIOFILCHEM® | 5/12 días | 1.163,34 | 1 | |
| 2135101711 | Brilliant Green / S.S., 20 plates 90 mm, Ready culture media in two sectors petri dishes, 50 cajas, LIOFILCHEM® | 5/12 días | 1.422,09 | 1 | |
| 2135101712 | Brilliant Green / S.S., 100 plates 90 mm, Ready culture media in two sectors petri dishes, 10 cajas, LIOFILCHEM® | 5/12 días | 1.439,34 | 1 | |
| 2135101713 | CDC Anaerobic Agar / CDC wKanamycin-Vancomyc, 20 plates 90 mm, Ready culture media in two sectors petri dishes, 40 cajas, LIOFILCHEM® | 5/12 días | 2.474,34 | 1 | |
| 2135101714 | Chocolate Agar /Thayer Martin, 20 plates 90 mm, Ready culture media in two sectors petri dishes, 50 cajas, LIOFILCHEM® | 5/12 días | 1.439,34 | 1 | |
| 2135101715 | Chromatic™ CRE / Chromatic™ ESBL, 20 plates 90 mm, Chromogenic culture media, Chromogenic media on double plate for detecting carbapenem-resistant Enterobacteriaceae and Extended Spectrum Beta-Lactamase producing bacteria, 1 cajas, LIOFILCHEM® | 5/12 días | 114,54 | 1 | |
| 2135101716 | Chromatic™ CRE / Chromatic™ ESBL, 100 plates 90 mm, Chromogenic culture media, Chromogenic media on double plate for detecting carbapenem-resistant Enterobacteriaceae and Extended Spectrum Beta-Lactamase producing bacteria, 1 cajas, LIOFILCHEM® | 5/12 días | 266,34 | 1 | |
| 2135101717 | Chromatic™ CRE / Chromatic™ OXA-48, 20 plates 90 mm, Chromogenic culture media, Chromogenic medium for the detection of carbapenem-resistant Enterobacteriaceae and screening of OXA-48 carbapenemase producing Enterobacteriaceae, 40 cajas, LIOFILCHEM® | 5/12 días | 2.819,34 | 1 | |
| 2135101718 | Chromatic™ Detection / Chromatic™ ESBL, 20 plates 90 mm, Chromogenic culture media, Chromogenic media on double plate for urinary bacterial count and identification and for detecting Extended Spectrum Beta-Lactamase producing bacteria, 40 cajas, LIOFILCHEM® | 5/12 días | 1.853,34 | 1 | |
| 2135101719 | Chromatic™ Staph.aureus / Chromatic™ MRSA, 20 plates 90 mm, Chromogenic culture media, Chromogenic media on double plate for detecting methicillin-resistant Staphylococcus aureus, 40 cajas, LIOFILCHEM® | 5/12 días | 2.129,34 | 1 | |
| 2135101720 | Cled / MacConkey, 20 plates 90 mm, Ready culture media in two sectors petri dishes, 50 cajas, LIOFILCHEM® | 5/12 días | 1.422,09 | 1 | |
| 2135101721 | Cled / MacConkey, 100 plates 90 mm, Ready culture media in two sectors petri dishes, 10 cajas, LIOFILCHEM® | 5/12 días | 1.439,34 | 1 | |
| 2135101722 | Cled / TSA Blood, 20 plates 90 mm, Ready culture media in two sectors petri dishes, 8 cajas, LIOFILCHEM® | 5/12 días | 262,26 | 1 | |
| 2135101723 | Columbia C.N.A. / Chocolate, 20 plates 90 mm, Ready culture media in two sectors petri dishes, 50 cajas, LIOFILCHEM® | 5/12 días | 1.422,09 | 1 | |
| 2135101724 | Columbia C.N.A. / Chocolate, 100 plates 90 mm, Ready culture media in two sectors petri dishes, 10 cajas, LIOFILCHEM® | 5/12 días | 1.439,34 | 1 | |
| 2135101725 | Columbia C.N.A. / GARDNERELLA V., 20 plates 90 mm, Ready culture media in two sectors petri dishes, 50 cajas, LIOFILCHEM® | 5/12 días | 1.422,09 | 1 | |
| 2135101726 | Columbia C.N.A. / GARDNERELLA V., 100 plates 90 mm, Ready culture media in two sectors petri dishes, 10 cajas, LIOFILCHEM® | 5/12 días | 1.439,34 | 1 | |
| 2135101727 | Columbia C.N.A. / MacConkey, 20 plates 90 mm, Ready culture media in two sectors petri dishes, 50 cajas, LIOFILCHEM® | 5/12 días | 1.422,09 | 1 | |
| 2135101728 | Columbia C.N.A. / MacConkey, 100 plates 90 mm, Ready culture media in two sectors petri dishes, 10 cajas, LIOFILCHEM® | 5/12 días | 1.439,34 | 1 | |
| 2135101729 | D.T.M. / Sabouraud, 20 plates 90 mm, Ready culture media in two sectors petri dishes, 50 cajas, LIOFILCHEM® | 5/12 días | 1.422,09 | 1 | |
| 2135101730 | D.T.M. / Sabouraud, 100 plates 90 mm, Ready culture media in two sectors petri dishes, 10 cajas, LIOFILCHEM® | 5/12 días | 1.439,34 | 1 | |
| 2135101731 | EMB Levine / T.S.A. Blood, 20 plates 90 mm, Ready culture media in two sectors petri dishes, 40 cajas, LIOFILCHEM® | 5/12 días | 1.073,92 | 1 | |
| 2135101732 | EMB Levine / T.S.A. Blood, 100 plates 90 mm, Ready culture media in two sectors petri dishes, 8 cajas, LIOFILCHEM® | 5/12 días | 638,94 | 1 | |
| 2135101733 | Enterococcus Screen Agar 4 sectors, 20 plates 90 mm, Four media in one plate for detecting high level Vancomycin and Aminoglycoside resistant enterococci, 50 cajas, LIOFILCHEM® | 5/12 días | 3.509,34 | 1 | |
| 2135101734 | GARDNERELLA V. / Thayer Martin, 20 plates 90 mm, Ready culture media in two sectors petri dishes, 50 cajas, LIOFILCHEM® | 5/12 días | 1.422,09 | 1 | |
| 2135101735 | GARDNERELLA V. / Thayer Martin, 100 plates 90 mm, Ready culture media in two sectors petri dishes, 10 cajas, LIOFILCHEM® | 5/12 días | 1.439,34 | 1 | |
| 2135101736 | HEKTOEN ENTERIC / YERSINIA, 20 plates 90 mm, Ready culture media in two sectors petri dishes, 50 cajas, LIOFILCHEM® | 5/12 días | 1.422,09 | 1 | |
| 2135101737 | HEKTOEN ENTERIC / YERSINIA, 100 plates 90 mm, Ready culture media in two sectors petri dishes, 10 cajas, LIOFILCHEM® | 5/12 días | 1.439,34 | 1 | |
| 2135101738 | HEKTOEN ENTERIC / S.S., 20 plates 90 mm, Ready culture media in two sectors petri dishes, 50 cajas, LIOFILCHEM® | 5/12 días | 1.422,09 | 1 | |
| 2135101739 | HEKTOEN ENTERIC / S.S., 100 plates 90 mm, Ready culture media in two sectors petri dishes, 10 cajas, LIOFILCHEM® | 5/12 días | 1.439,34 | 1 | |
| 2135101740 | MacConkey / Sabouraud CAF, 20 plates 90 mm, Ready culture media in two sectors petri dishes, 50 cajas, LIOFILCHEM® | 5/12 días | 1.422,09 | 1 | |
| 2135101741 | MacConkey / Leifson, 20 plates 90 mm, Ready culture media in two sectors petri dishes, 10 cajas, LIOFILCHEM® | 5/12 días | 576,84 | 1 | |
| 2135101742 | MacConkey / S.S. Agar, 20 plates 90 mm, Ready culture media in two sectors petri dishes, 50 cajas, LIOFILCHEM® | 5/12 días | 1.422,09 | 1 | |
| 2135101743 | MacConkey / S.S. Agar, 100 plates 90 mm, Ready culture media in two sectors petri dishes, 10 cajas, LIOFILCHEM® | 5/12 días | 1.439,34 | 1 | |
| 2135101744 | MacConkey / T.S.A. Blood, 20 plates 90 mm, Ready culture media in two sectors petri dishes, 50 cajas, LIOFILCHEM® | 5/12 días | 1.422,09 | 1 | |
| 2135101745 | MacConkey / T.S.A. Blood, 100 plates 90 mm, Ready culture media in two sectors petri dishes, 8 cajas, LIOFILCHEM® | 5/12 días | 1.163,34 | 1 | |
| 2135101746 | MacConkey / Baird Parker / T.S.A. Blood, 20 plates 90 mm, Ready culture media in two sectors petri dishes, 50 cajas, LIOFILCHEM® | 5/12 días | 1.603,56 | 1 | |
| 2135101747 | T.S.A. Blood / Chromatic™ Detection, 20 plates 90 mm, Ready culture media in two sectors petri dishes, 50 cajas, LIOFILCHEM® | 5/12 días | 2.646,84 | 1 | |
| 2135101748 | T.S.A. Blood / Chromatic™ Detection, 100 plates 90 mm, Ready culture media in two sectors petri dishes, 10 cajas, LIOFILCHEM® | 5/12 días | 2.284,59 | 1 | |
| 2135101749 | T.S.A. II +5% Sheep Blood / MacConkey MUG, 20 plates 90 mm, Ready culture media in two sectors petri dishes, 40 cajas, LIOFILCHEM® | 5/12 días | Consultar | 1 | |
| 2135101750 | Baird Parker / BIGGY / MacConkey, 20 plates 90 mm, Ready culture media in three sectors petri dishes, 50 cajas, LIOFILCHEM® | 5/12 días | 1.870,59 | 1 | |
| 2135101751 | Baird Parker / BIGGY / MacConkey, 100 plates 90 mm, Ready culture media in three sectors petri dishes, 10 cajas, LIOFILCHEM® | 5/12 días | 1.508,34 | 1 | |
| 2135101752 | Baird Parker / Bile Esculine / Sabouraud CAF, 20 plates 90 mm, Ready culture media in three sectors petri dishes, 50 cajas, LIOFILCHEM® | 5/12 días | 1.870,59 | 1 | |
| 2135101753 | Baird Parker / Bile Esculine / Sabouraud CAF, 100 plates 90 mm, Ready culture media in three sectors petri dishes, 10 cajas, LIOFILCHEM® | 5/12 días | 1.508,34 | 1 | |
| 2135101754 | Baird Parker / MacConkey / Sabouraud CAF, 20 plates 90 mm, Ready culture media in three sectors petri dishes, 50 cajas, LIOFILCHEM® | 5/12 días | 1.870,59 | 1 | |
| 2135101755 | Baird Parker / MacConkey / Sabouraud CAF, 100 plates 90 mm, Ready culture media in three sectors petri dishes, 10 cajas, LIOFILCHEM® | 5/12 días | 1.508,34 | 1 | |
| 2135101756 | Brom Cresol Purple / Columbia CNA / M.Conkey, 20 plates 90 mm, Ready culture media in two sectors petri dishes, 50 cajas, LIOFILCHEM® | 5/12 días | 1.870,59 | 1 | |
| 2135101757 | Brom Cresol Purple / Columbia CNA / M.Conkey, 100 plates 90 mm, Ready culture media in two sectors petri dishes, 10 cajas, LIOFILCHEM® | 5/12 días | 1.508,34 | 1 | |
| 2135101758 | Columbia CNA / Chocolate / Thayer Martin, 20 plates 90 mm, Ready culture media in three sectors petri dishes, 50 cajas, LIOFILCHEM® | 5/12 días | 1.870,59 | 1 | |
| 2135101759 | Columbia CNA / Chocolate / Thayer Martin, 100 plates 90 mm, Ready culture media in three sectors petri dishes, 10 cajas, LIOFILCHEM® | 5/12 días | 1.508,34 | 1 | |
| 2135101760 | Choc Bac. / Columbia / MacConkey, 20 plates 90 mm, Ready culture media in three sectors petri dishes, 40 cajas, LIOFILCHEM® | 5/12 días | 1.362,06 | 1 | |
| 2135101761 | Choc Bac. / Columbia / MacConkey, 100 plates 90 mm, Ready culture media in three sectors petri dishes, 8 cajas, LIOFILCHEM® | 5/12 días | 1.334,46 | 1 | |
| 2135101762 | Gardnerella V. / Chocolate / Thayer Martin, 20 plates 90 mm, Ready culture media in three sectors petri dishes, 50 cajas, LIOFILCHEM® | 5/12 días | 2.129,34 | 1 | |
| 2135101763 | Cled / MacConkey / ENTEROCOCCO, 20 plates 90 mm, Ready culture media in three sectors petri dishes, 50 cajas, LIOFILCHEM® | 5/12 días | 1.870,59 | 1 | |
| 2135101764 | Cled / MacConkey / ENTEROCOCCO, 100 plates 90 mm, Ready culture media in three sectors petri dishes, 10 cajas, LIOFILCHEM® | 5/12 días | 1.508,34 | 1 | |
| 2135101765 | Cled / MacConkey / Cetrimide, 20 plates 90 mm, Ready culture media in three sectors petri dishes, 50 cajas, LIOFILCHEM® | 5/12 días | 1.870,59 | 1 | |
| 2135101766 | Cled / MacConkey / Cetrimide, 100 plates 90 mm, Ready culture media in three sectors petri dishes, 10 cajas, LIOFILCHEM® | 5/12 días | 1.508,34 | 1 | |
| 2135101767 | Cled / MacConkey MUG / Malto, 20 plates 90 mm, Ready culture media in three sectors petri dishes, 50 cajas, LIOFILCHEM® | 5/12 días | 1.689,81 | 1 | |
| 2135101768 | Cled / MacConkey MUG / Malto, 100 plates 90 mm, Ready culture media in three sectors petri dishes, 10 cajas, LIOFILCHEM® | 5/12 días | 1.653,24 | 1 | |
| 2135101769 | Cled / MacConkey / TSA Blood, 20 plates 90 mm, Ready culture media in three sectors petri dishes, 50 cajas, LIOFILCHEM® | 5/12 días | 1.603,56 | 1 | |
| 2135101770 | Cled / MacConkey / TSA Blood, 100 plates 90 mm, Ready culture media in three sectors petri dishes, 10 cajas, LIOFILCHEM® | 5/12 días | 1.508,34 | 1 | |
| 2135101771 | GARDNERELLA V. / Rogosa / Thayer Martin, 20 plates 90 mm, Ready culture media in three sectors petri dishes, 50 cajas, LIOFILCHEM® | 5/12 días | 1.870,59 | 1 | |
| 2135101772 | GARDNERELLA V. / Rogosa / Thayer Martin, 100 plates 90 mm, Ready culture media in three sectors petri dishes, 10 cajas, LIOFILCHEM® | 5/12 días | 1.508,34 | 1 | |
| 2135101773 | GROUP A SELECTIVE / TSA II Sheep Blood 5%, 20 plates 90 mm, Ready culture media in three sectors petri dishes, 50 cajas, LIOFILCHEM® | 5/12 días | 2.646,84 | 1 | |
| 2135101774 | MacConkey / V. JOHNSON / Sabouraud, 20 plates 90 mm, Ready culture media in three sectors petri dishes, 50 cajas, LIOFILCHEM® | 5/12 días | 1.870,59 | 1 | |
| 2135101775 | MacConkey / V. JOHNSON / Sabouraud, 100 plates 90 mm, Ready culture media in three sectors petri dishes, 10 cajas, LIOFILCHEM® | 5/12 días | 1.508,34 | 1 | |
| 2135101776 | MSA / Chromatic MRSA, 20 plates 90 mm, Ready culture media in three sectors petri dishes, 1 cajas, LIOFILCHEM® | 5/12 días | 114,54 | 1 | |
| 2135101777 | Schaedler K / Schaedler KKV, 20 plates 90 mm, Ready culture media in three sectors petri dishes, 1 cajas, LIOFILCHEM® | 5/12 días | 114,54 | 1 |